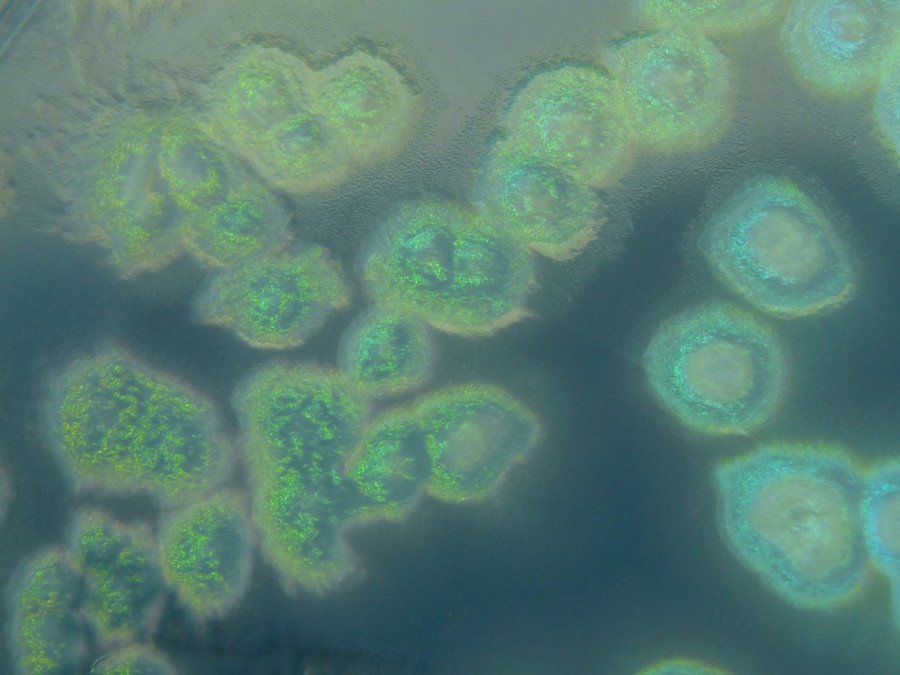
Pseudomonas aeruginosa Créditos: By HansN. - Own work, CC BY-SA 3.0, https://commons.wikimedia.org/w/index.php?curid=23249600

La resistencia antibiótica es una de las mayores amenazas para la salud pública, especialmente en bacterias como Pseudomonas aeruginosa, contra la cual hay pocos antibióticos eficaces. En este estudio se usó un compuesto análogo de oligonucleótido, un PPNA, para silenciar un gen de la bacteria que es esencial para habilitar el mecanismo de resistencia más habitual: la hiperexpresión de su enzima betalactamasa AmpC. La exposición al PPNA inhibió este mecanismo, restaurando la sensibilidad de cepas de P. aeruginosa resistentes a los antibióticos betalactámicos.
La resistencia a los antibióticos es una de las principales amenazas para la salud pública. La OMS estima que, si no se desarrollan nuevas estrategias, para 2050 se darán hasta 10 millones de muertes al año asociadas a infecciones por patógenos resistentes. Entre las bacterias más preocupantes en este sentido destaca Pseudomonas aeruginosa, clasificada como patógeno de alta prioridad para el desarrollo de nuevos antimicrobianos. Esta especie oportunista intrahospitalaria es un desafío terapéutico creciente pues es capaz de desarrollar resistencia a todos los betalactámicos, los antibióticos más utilizados a nivel global.
Estrategias anti-resistencia para restaurar la eficacia de los antibióticos
La capacidad de la bacteria para adquirir genes de resistencia horizontalmente y acumular mutaciones que alteren su permeabilidad, que causen hiperexpresión de bombas de expulsión de fármacos o de su enzima para destruir a los antibióticos betalactámicos, la betalactamasa AmpC, hacen que éstos hayan perdido gran parte de su efectividad, subrayando la necesidad de terapias alternativas. Entre éstas destacan las estrategias anti-resistencia, que persiguen bloquear ciertos mecanismos para restaurar la eficacia de antibióticos que están cerca de quedar obsoletos para su uso contra las infecciones por P. aeruginosa, como es el caso de algunos betalactámicos como la ceftazidima.
El principal mecanismo de resistencia a antibióticos betalactámicos de P. aeruginosa es la mencionada hiperexpresión de su enzima betalactamasa AmpC por encima de su nivel basal, obtenida gracias a mutaciones ligadas al metabolismo de la pared celular. La enzima AmpC está regulada a través de ciertos fragmentos solubles (muropéptidos) que se liberan de la pared en su proceso de degradación natural, y que deben ser internalizados y metabolizados en el citosol (medio líquido que se encuentra en el interior de las células) para habilitar una señalización —a través del regulador transcripcional AmpR— que activa la hiperexpresión del gen ampC y por tanto la resistencia.
Existen determinados intermediarios esenciales para este proceso, como la enzima NagZ, que realiza su actividad en el citosol y permite una reacción clave para dotar a los muropéptidos de capacidad activadora de AmpC. En concordancia, previamente se demostró que el noqueo de NagZ en P. aeruginosa deshabilita la resistencia a antibióticos betalactámicos que depende de la enzima AmpC, al bloquear su hiperproducción. Además, al ser la enzima NagZ clave para la reconstrucción de la pared, su noqueo mostró efectos atenuantes de la virulencia de la bacteria, por el coste biológico que conlleva la alteración de esa reconstrucción, sugiriendo que puede tener potencial como diana anti-virulencia.
Rehabilitar fármacos
Así pues, inhibir la producción y la actividad de la enzima NagZ en cepas de P. aeruginosa hiperproductoras de la enzima AmpC permitiría disminuir la expresión de ésta y, por tanto, su resistencia derivada, rehabilitando fármacos como la ceftazidima.
A pesar de que se han diseñado inhibidores enzimáticos de NagZ, éstos nunca han acabado de ser exitosos. Por ello, como estrategia diferente, en este estudio consideramos el uso de un tipo de análogo de oligonucleótido denominado PPNA (peptide-conjugated peptide nucleic acid) dirigido a reprimir la traducción del gen nagZ. Los PPNAs pueden atravesar las envolturas bacterianas, y tienen una secuencia específica que inhibe la traducción del gen diana, al hibridar con su ARN mensajero e impedir su interacción con el ribosoma.
Nuestro análogo de nucleótido PPNA se evaluó utilizando cepas de la bacteria hiperproductoras de la enzima AmpC y, por tanto, resistentes al antibiótico ceftazidima. A una concentración determinada (de 2 micromolar), el PPNA redujo los niveles de ARN mensajero de los genes nagZ y ampC a aproximadamente un 25 % en un mutante de laboratorio y en una cepa clínica, hiperproductores de la enzima AmpC de alto nivel.
La concentración de 2 micromolar de PPNA combinada con el antibiótico redujo la concentración mínima necesaria para inhibir el crecimiento de la bacteria (de 64 a 8 microgramos por mililitro) en ambas cepas, demostrando una gran sinergia.
Poca toxicidad en células humanas
Además, el análogo de nucleótido PPNA propuesto en nuestra investigación mostró poca toxicidad sobre células humanas en ensayos de cuantificación de muerte celular (por debajo del 10 %), lo que incrementa su potencial terapéutico. Estos datos sugieren un futuro esperanzador para para los análogos de nucleótido PPNA dirigidos a silenciar la producción de la enzima AmpC, que deberán ser testados en modelos animales y en diferentes formulaciones para corroborar su validez para contrarrestar la resistencia de P. aeruginosa a los antibióticos y su potencial como estrategia anti-virulencia.
Referencia:
Escobar-Salom, M., Barceló, I. M., Sansó-Sastre, J., Torrens, G., Jordana-Lluch, E., Moyà, B., Oliver, A., & Juan, C. (2025). An antisense peptide-conjugated peptide nucleic acid (PPNA) for peptidoglycan recycling inhibition reduces AmpC hyperproduction and β-lactam resistance in Pseudomonas aeruginosa. Microbiology spectrum, 13(9), e0262224. https://doi.org/10.1128/spectrum.02622-24
Imagen:
Pseudomonas aeruginosa Créditos: By HansN. – Own work, CC BY-SA 3.0, https://commons.wikimedia.org/w/index.php?curid=23249600
Autores del artículo divulgativo:
Maria Escobar Salom, Isabel Maria Barceló, Elena Jordana Lluch, Bartolomé Moyà,
Antonio Oliver y Carlos Juan
ARPBIG group
Health Research Institute of the Balearic Islands (IdISBa),
Microbiology Department, University Hospital Son Espases (HUSE)
Centro de Investigación Biomédica en Red, Área Enfermedades Infecciosas (CIBERINFEC), Instituto de Salud Carlos III (ISCIII)
Jordi Sansó Sastre
ARPBIG group
Health Research Institute of the Balearic Islands (IdISBa),
Microbiology Department, University Hospital Son Espases (HUSE)
Gabriel Torrens
Department of Molecular Biology and Laboratory for Molecular Infection Medicine
Sweden (MIMS)
Umeå Centre for Microbial Research (UCMR), Umeå University (Sweden)
Fuente: Scientias
Artículo bajo licencia Creative Commons – Atribución (CC BY 4.0). Este artículo puede ser reproducido íntegramente siempre y cuando vaya firmado por los autores y se acredite SCIENTIAS como fuente, incluyendo el enlace a nuestra página.